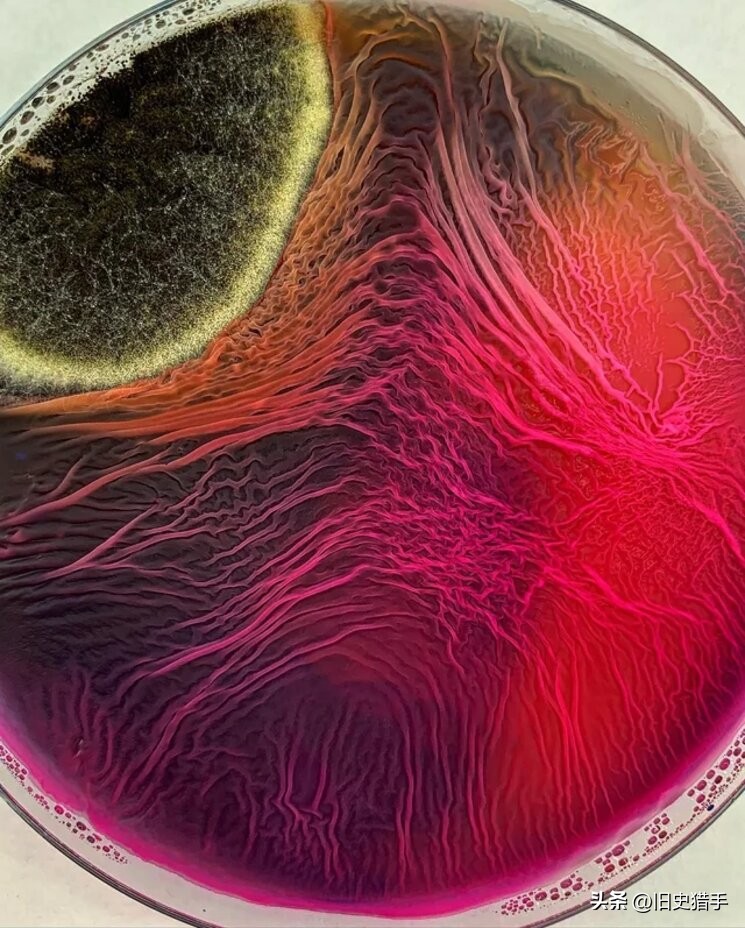
20张照片霉霉,25张令人震惊的图片

话说在我们生活中到处都能看到各种霉菌,例如没洗的锅碗瓢盆,潮湿的角落,放得太久的各种食物等等,都能看到各种各样的霉菌霉斑。通常霉菌都是令人讨厌的,毕竟看到它就意味着食物变质了,还容易让人生病,不过在摄影师的镜头下,霉菌却呈现出一片异样的美丽。
下面这25张罕见的霉菌照片,将会让你充分感受到这种既美丽,又危险的神奇生物,颠覆你对霉菌的想象:
1.向日葵在烤箱里放了足足一个月后,长出了一团白色的霉菌,就像藏了一朵云一样。

2.两个月的时间,大自然“煮”出了一锅霉菌。

3.长出毛发的草莓…画风也太诡异了。

4.在冰箱里放了好几天的蔬菜汤,上面长满了奇怪的霉菌。

5.一只不知放了多久的苹果,变得就像起皱的化石一样,上面还有斑斑点点的霉菌。

6.这就是绿茶发霉后的样子…

7.厨房里被遗忘的一碗罗宋汤,看起来太掉SAN了…

8.中间发霉的橙子,感觉像是被毒液寄生了一样。

9.当泡酸菜盐放得不够时,就容易变质长出一层霉菌。

10.保存不当的奶油奶酪,上面覆盖着一层“美味”的霉菌。

11.绿色的发霉乳酪,看起来竟然有点像一块造型奇特的蛋糕。

12.腐烂木头上长出了一簇簇“头发”…

13.神奇的霉菌,竟然自然形成了一张网络,就像大脑的神经元一样,不知道它们会不会进化出智慧呢?

14.香肠上的霉斑,看上去既美丽又让人不舒服。

15.樱桃酱上的霉菌,感觉披了一层不知名的粉末一样。

16.显微镜下的粉红色霉菌,对于微生物来说,这算不算是参天大树呢?

17.发霉的土豆,竟然长出了像头发丝一样的真菌,太瘆人了…

18.放了一个多月没洗的汤锅,感觉就像是被外星生物寄生了一样…

19.从一罐猫粮里长出来的奇异霉菌,半夜看到这个估计会被吓死…

20.令人惊叹的天然“霉菌艺术”,既美丽又充满危险..
21.一棵发霉的甜菜,竟然有点像一个造型别致的甜点。

22.一周没洗的炖锅,里面竟然长满了白毛…从此以后再也不敢不洗锅了..

23.一张发霉的桌子,看着有点像一幅意义不明的油画。

24.霉化了一半的柠檬,身上自带了一层渐变色。

25.被遗忘的意大利面,上面长出了一朵“棉花”。

只能说大自然真是充满了各种奇妙的生物~